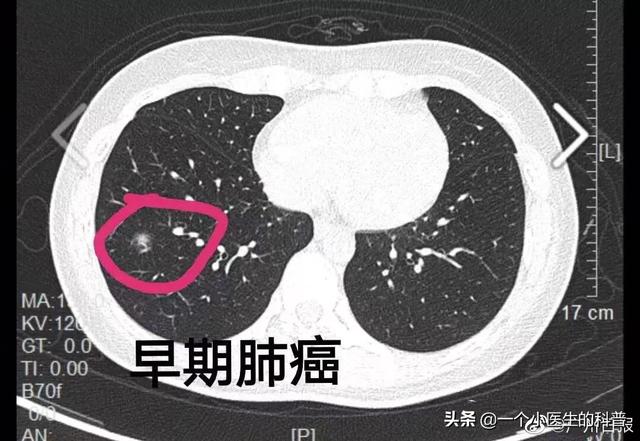

Pourquoi n'existe-t-il pas de médicaments ciblés pour traiter l'adénocarcinome pulmonaire ?
Pourquoi n'existe-t-il pas de médicaments ciblés pour traiter l'adénocarcinome pulmonaire ?
Bonjour, je suis un petit docteur en sciences et en tant que professionnel de la santé, je vais répondre à cette question
Avant de répondre à cette question, il est important d'examiner la classification du cancer du poumon.
L'adénocarcinome dont il est question dans cette question est un type de cancer du poumon.
En fait, les types courants de cancer du poumon sont le carcinome malpighien, l'adénocarcinome, le cancer du poumon à petites cellules et le carcinome à grandes cellules.

Commençons par vous donner les caractéristiques de chaque cancer :
- Carcinome malpighien : anciennement le cancer le plus fréquent en Chine, il est étroitement lié au tabagisme et se manifeste principalement sous la forme d'un cancer central du poumon. Il se développe généralement lentement et ne donne pas facilement de métastases dans les premiers stades.
- Adénocarcinome : le cancer le plus fréquent de nos jours, les femmes d'âge moyen étant les plus exposées au cancer du poumon, qui a tendance à se métastaser à un stade précoce, mais grâce à l'émergence de médicaments ciblés, le pronostic est aujourd'hui meilleur pour les cancers du poumon avancés.
- Cancer du poumon à petites cellules : le pire des pronostics, facile à métastaser à un stade précoce, très mauvais pronostic, pas de médicaments ciblés.
- Cancer du poumon à grandes cellules : pronostic plus défavorable que les cancers épidermoïdes et les adénocarcinomes.
Médicaments ciblés pour l'adénocarcinome
L'adénocarcinome est le plus chanceux des nombreux types de cancer du poumon, et ce grâce à l'avènement des médicaments ciblés.
Dans notre esprit, les médicaments ciblés se réfèrent généralement à ceux qui présentent des mutations de l'EGFR et de l'ALK.
Les médicaments angiogéniques antitumoraux ne sont pas inclus.
La plus courante est la mutation de l'EGFR, que l'on retrouve dans 50 % de nos adénocarcinomes :
Il existe actuellement trois générations de ce médicament ciblé :
Les trois médicaments de première génération sont le géfitinib, souvent appelé erlotinib, l'erlotinib, souvent appelé trocar, et l'ectinib.
Il existe deux types de deuxième génération, l'afatinib et le daclotinib.
. La troisième génération est l'ositinib, qui est très efficace, surtout dans la troisième génération.
S'il s'agit d'une mutation ALK, c'est une mutation Oak, et vous pouvez utiliser le crizotinib, le ceritinib, le buclatinib, le loratinib, l'alectinib, etc.
Avantages et inconvénients de la thérapie ciblée
La thérapie ciblée présente l'avantage d'être pratique et efficace.
L'épidémie peut être contrôlée en prenant un comprimé par jour, et on peut dire qu'il n'y a pratiquement pas d'impact sur la qualité de vie, ce qui explique que l'observance médicale du patient soit très bonne.
Lorsqu'il est efficace à un stade précoce, les résultats sont très bons, voire surprenants, et l'on peut constater que les symptômes cliniques du patient s'améliorent nettement et que le scanner thoracique peut montrer que la masse se réduit rapidement, voire qu'elle disparaît.
Mais les inconvénients des thérapies ciblées sont également très évidents, le plus important étant la résistance aux médicaments.
On peut dire que toutes les personnes qui utilisent des médicaments ciblés développent une résistance, ce n'est qu'une question de temps, 9 à 11 mois pour une personne moyenne.
C'est pourquoi les médicaments ciblés ne cessent d'augmenter.
De plus, les médicaments ciblés ne peuvent pas éradiquer le cancer du poumon, ce qui signifie qu'il n'y a pas de remède.
Dans le même temps, les nouveaux médicaments ciblés sont coûteux et inabordables pour de nombreuses personnes, ce qui pousse beaucoup d'entre elles à choisir des médicaments indiens.
Existe-t-il d'autres traitements pour l'adénocarcinome avancé ?
La réponse est certainement là, et puisque le sujet a dit qu'il s'agissait d'une thérapie ciblée, elle doit être avancée, ou au moins localement avancée.
Il existe deux autres moyens de traiter l'adénocarcinome avancé : la radiothérapie et l'immunothérapie.
- Tout le monde devrait connaître la radiothérapie, et il y a même ceux qui la diabolisent, mais ce qui est certain, c'est qu'elle est efficace.
- Immunothérapie : l'immunothérapie est également une nouvelle modalité de traitement apparue ces dernières années. Cependant, le taux d'efficacité de l'immunothérapie est relativement faible, mais une fois efficace, elle dure longtemps. On peut dire qu'il s'agit d'une forme de traitement très prometteuse. Mais le prix élevé est également un gros problème, que les gens ordinaires ne peuvent pas se permettre.
Le meilleur moyen de lutter contre le cancer du poumon est le dépistage précoce.
Le meilleur moyen de lutter contre le cancer du poumon est le dépistage précoce, et le taux de survie à cinq ans pour un cancer du poumon à un stade précoce est supérieur à 95 %.
Le meilleur moyen de détecter un cancer du poumon à un stade précoce est de réaliser un scanner des poumons.
Le scanner pulmonaire ne coûte pas plus de 200 euros par an, mais s'il détecte un cancer du poumon à un stade précoce, il vous sauvera la vie.
Je recommande à toutes les personnes âgées de plus de 40 ans de passer chaque année un scanner des poumons.
Tous les patients atteints d'adénocarcinome pulmonaire ne disposent pas d'un médicament ciblé, en raison des différences de génotypage.
Le cancer du poumon est une maladie qui touche tout le monde, et tous les cancers du poumon sont identiques.
Ce n'est pas vraiment vrai.
Dans le passé, nous distinguions principalement le cancer du poumon par typage moléculaire, divisant le cancer du poumon en deux catégories principales : le cancer du poumon à petites cellules et le cancer du poumon non à petites cellules, et le cancer du poumon non à petites cellules était encore divisé enAdénocarcinomecarcinome squameux, carcinome à grandes cellules, carcinosarcome, etc.
Avec l'essor des thérapies ciblées au fil des ans, le typage du cancer du poumon a évolué vers le génotypage, ce qui signifie que des cancers du poumon présentant la même pathologie moléculaire sont génotypés différemment.
Prenez les poumons mentionnés dans le titreAdénocarcinomePar exemple, il peut être divisé en différents types de mutations génétiques, dont ceux pour lesquels des médicaments ciblés sont disponibles se réfèrent principalement aux deux principaux types de mutations des gènes EGFR et ALK. Pour les autres types de mutations, certains médicaments ciblés sont également disponibles, mais il n'existe pas de médicaments à l'efficacité précise en Chine.
Les médicaments thérapeutiques ciblés visent précisément le type de cancer du poumon présentant la mutation génétique susmentionnée, et ce point de mutation génétique est le point cible de l'attaque médicamenteuse. Lorsque les médicaments ciblés tuent les cellules, ils n'ont un effet destructeur que sur les cellules cancéreuses présentant cette mutation, et ont moins d'effet sur les cellules cancéreuses ne présentant pas la mutation génétique, y compris les cellules normales, et leur pouvoir destructeur est faible.
Par conséquent, les avantages des médicaments ciblés pour le traitement du cancer sont une plus grande précision et moins d'effets secondaires ; l'inconvénient est qu'ils ne sont efficaces que pour le cancer du poumon présentant une certaine mutation génétique, mais pas pour les autres types de cancer.
En conclusion, lors du diagnostic d'un adénocarcinome pulmonaire avancé, chaque patient doit subir un test génétique, dans le but de clarifier si le cancer dont il souffre appartient au type de mutation génétique mentionné ci-dessus. S'il est déterminé qu'il existe une mutation génétique sensible, le premier choix de traitement se porte sur les médicaments ciblés, et s'il n'y a pas de mutation génétique sensible, les médicaments ciblés sont inefficaces.

Pour répondre à cette question, nous devons tout d'abord comprendre la classification pathologique du cancer du poumon, qui est principalement classé en cancer du poumon non à petites cellules et en cancer du poumon à petites cellules, parmi lesquels les types courants de cancer du poumon non à petites cellules comprennent le cancer squameux du poumon, l'adénocarcinome du poumon, le cancer du poumon à grandes cellules ainsi que le cancer adénosquameux du poumon et le carcinome des glandes salivaires, entre autres, parmi lesquels l'adénocarcinome du poumon est le plus courant, et il est considéré comme une bénédiction parmi les malheurs si l'on a un adénocarcinome du poumon, et la bénédiction est qu'il y a plus de moyens de traitement pour l'adénocarcinome du poumon, y compris la chirurgie, le traitement ciblé, l'immunothérapie, la radiothérapie, la chimiothérapie et la médecine chinoise traditionnelle que pour les autres types de tumeurs. Heureusement, l'adénocarcinome pulmonaire dispose de plus de moyens de traitement, notamment la chirurgie, la thérapie ciblée, l'immunothérapie, la radiothérapie, la chimiothérapie et la médecine traditionnelle chinoise, que les autres types de cellules tumorales.

Pourquoi certains patients atteints d'adénocarcinome pulmonaire ne disposent-ils pas de médicaments ciblés ?
Les patients atteints d'un adénocarcinome pulmonaire avancé subissent régulièrement des tests génétiques avant d'être traités avec des médicaments ciblés. Les gènes habituellement mutés sont l'EGFR, l'ALK, le ROS1, le MET, la fusion RET, l'amplification HER2 et les mutations BRAF.
Les mutations de l'EGFR représentent environ 50 % des adénocarcinomes, et les mutations de ce locus sont rares dans les cancers squameux du poumon, dans lesquels apparaissent des adénocarcinomes pulmonaires. Les mutations de ce locus, qui présentent souvent des délétions aux loci l858r et 19, représentent environ 80 % des mutations, peuvent être traitées avec des médicaments ciblés de première génération, tels que le géfitinib et l'erlotinib, l'erlotinib, etc. et d'autres types de mutations comprennent L861Q, G719X, S768I, etc. et ces types de mutations sont généralement traités avec des médicaments ciblés de deuxième génération, l'alfatinib. D'autres types de mutations comprennent L861Q, G719X, S768I, etc., et ces types de mutations sont généralement traités avec l'alfatinib, un médicament ciblé de deuxième génération. Après un certain temps d'utilisation des médicaments ciblés de première et de deuxième génération, un phénomène de résistance aux médicaments se produit souvent, vous pouvez à nouveau effectuer des tests génétiques, environ 50 à 60 % des patients présenteront la mutation T790, vous pouvez alors choisir l'ositinib, un médicament ciblé de troisième génération, bien sûr, les dernières lignes directrices ont également proposé que vous puissiez utiliser la première ligne de médicaments ciblés de troisième génération pour le traitement des patients présentant des mutations de l'EGFR.

Bien sûr, après avoir utilisé l'ositinib pendant un certain temps, il y a toujours un phénomène de résistance aux médicaments, ce phénomène de résistance aux médicaments est souvent dû à la mutation C797S et à la mutation C-MET, HER2, dont la mutation C797S comprend la configuration cis et la configuration trans, si la configuration cis de la mutation, il n'y a généralement pas de médicaments ciblés qui peuvent être utilisés, si la configuration trans de la mutation, il peut être utilisé en même temps une génération et trois générations de médicaments ciblés. Si la mutation se trouve dans la configuration trans, les médicaments ciblés de première et de troisième génération peuvent être utilisés.
Si aucun des loci ci-dessus n'est muté, le médicament ciblé n'est pas recommandé.
L'adénocarcinome pulmonaire est le type de cancer du poumon le plus susceptible d'être traité par des médicaments ciblés, la possibilité de mutation du gène de l'adénocarcinome est relativement élevée, si l'adénocarcinome pulmonaire n'est pas traité par des médicaments ciblés, il est très probable qu'il n'y ait pas de mutation de la cible ou que la mutation de la cible n'ait pas de médicaments correspondants sur le marché.
La raison en est que la science actuelle est sous-développée et que les obstacles rencontrés ne peuvent être franchis. C'est la réalité d'un phénomène, de sorte que maintenant, pour guérir la maladie, de la cause de la maladie à la nature de chaque aspect d'un grand nombre d'informations, de littérature et de raisonnement, mais il n'y a aucun moyen de le faire, la raison en est que la science et la technologie actuelles ne peuvent pas atteindre ce niveau. Par exemple, un téléviseur est cassé, la personne moyenne peut le démonter mais ne peut toujours pas le réparer, car elle ne sait pas quoi faire en examinant tous les circuits.

Le même corps humain est une formation naturelle et non une conception humaine, pour l'homme comme pour la nature, il faut s'appuyer sur l'observation pour comprendre, puis sur le test réel pour expérimenter, mais aujourd'hui, la science atteint un niveau très bas, elle ne comprend pas le Yukon, c'est beaucoup. Mais aujourd'hui, la science a atteint un niveau très bas, elle ne comprend pas le Yukon, mais il n'y aura pas de texte zéro, au contraire, il y a beaucoup d'applications, comme le rêve, même l'interprétation des rêves par le duc de Zhou est comptée, les scientifiques disent aussi comptés, mais ne peuvent pas dire un si venir.

Les mêmes lésions des cellules cancéreuses qui touchent le système immunitaire et cellulaire du corps humain sont au cœur du problème. Aujourd'hui, la science ne peut pas commencer, elle ne peut pas comprendre, mais la littérature n'est pas nulle, il y aura un grand nombre de personnes qui diront que l'art de rapporter toutes sortes d'instructions, mais elles diront que cela ne peut pas être résolu, parce qu'elles ne diront pas que c'est juste ou faux, la compréhension actuelle n'est pas suffisante pour comprendre l'essence du problème plus que suffisante pour créer l'essence du médicament pour l'essence de l'essence de l'essence du problème n'est pas claire. L'essence n'est pas claire. Quelle est l'essence du traitement, il s'agit donc d'un traitement unique, de la radiothérapie, de la médecine chinoise pour voir les résultats. À l'avenir, lorsque la cause sera claire, il y aura des progrès.

Ces questions et réponses proviennent des utilisateurs du site, elles ne représentent pas la position du site, s'il y a une infraction, veuillez contacter l'administrateur pour la supprimer.